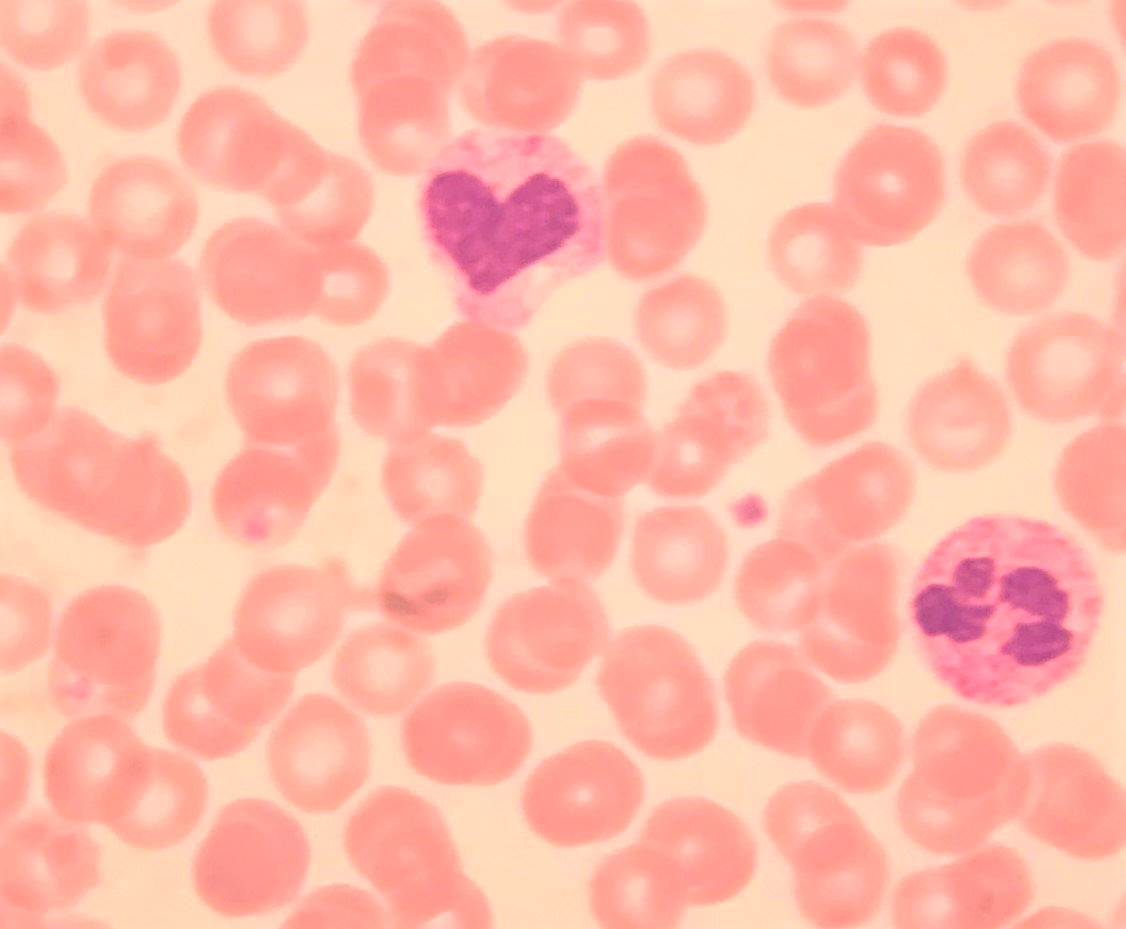
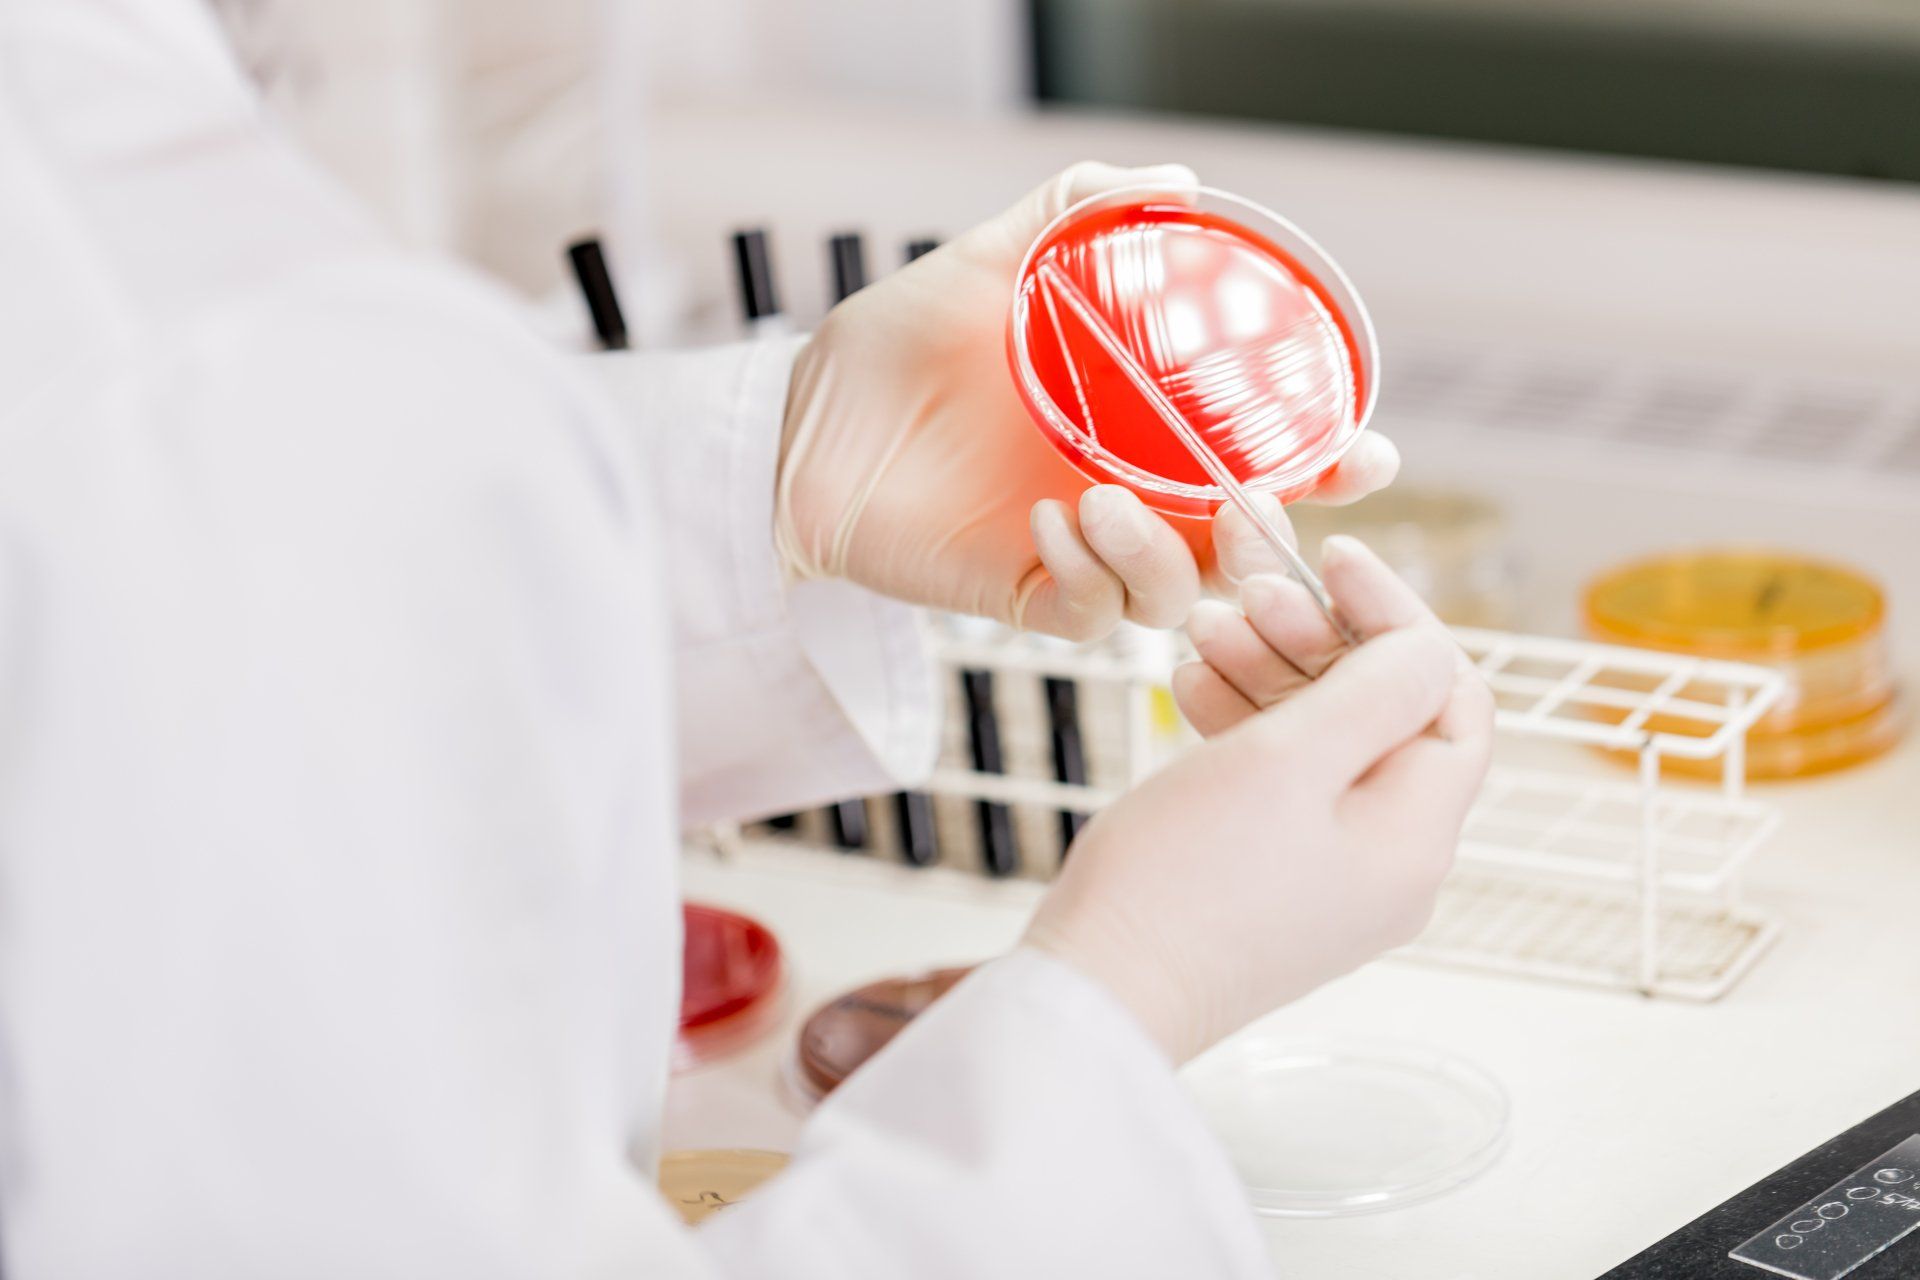
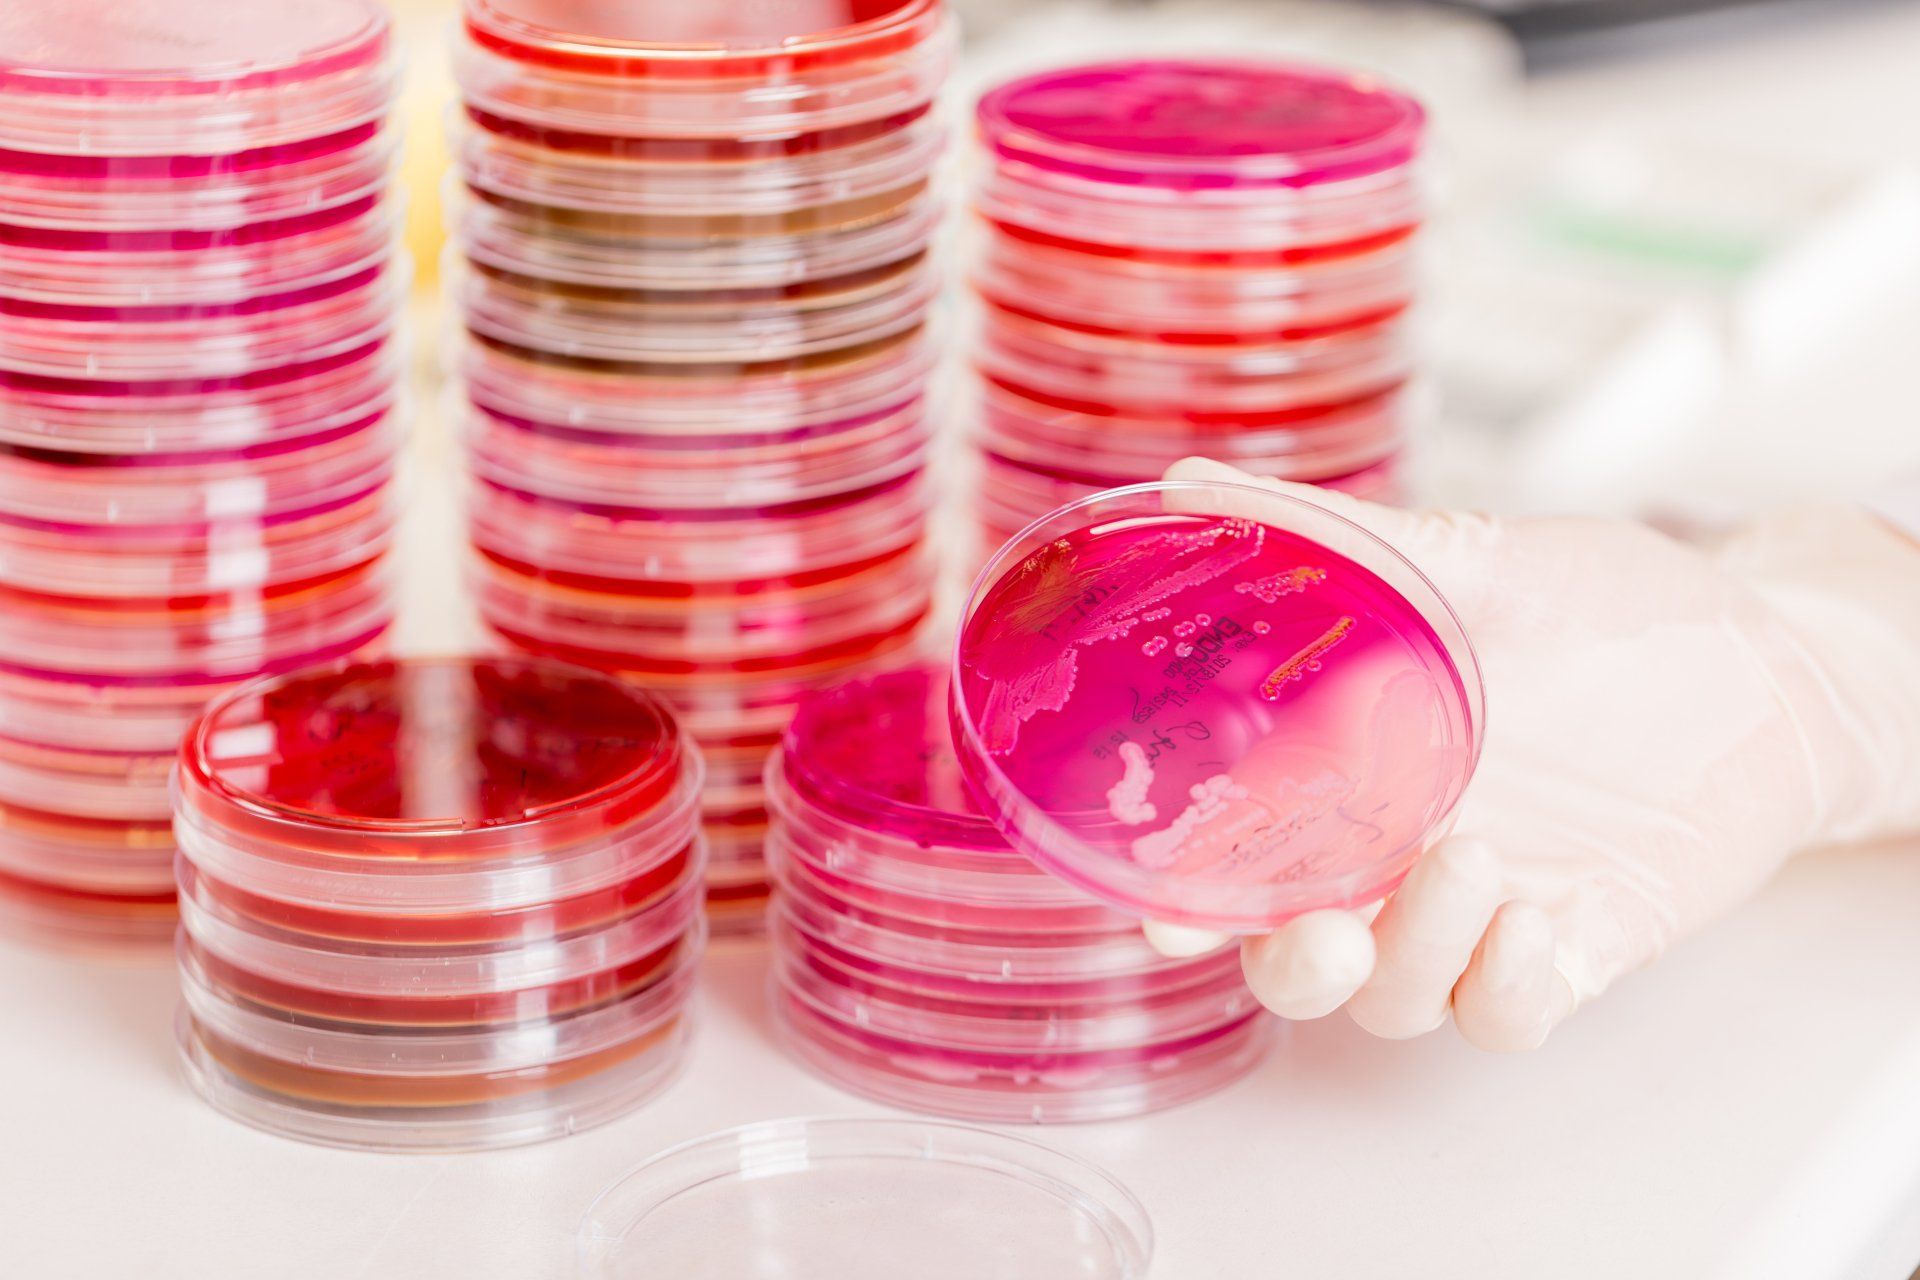
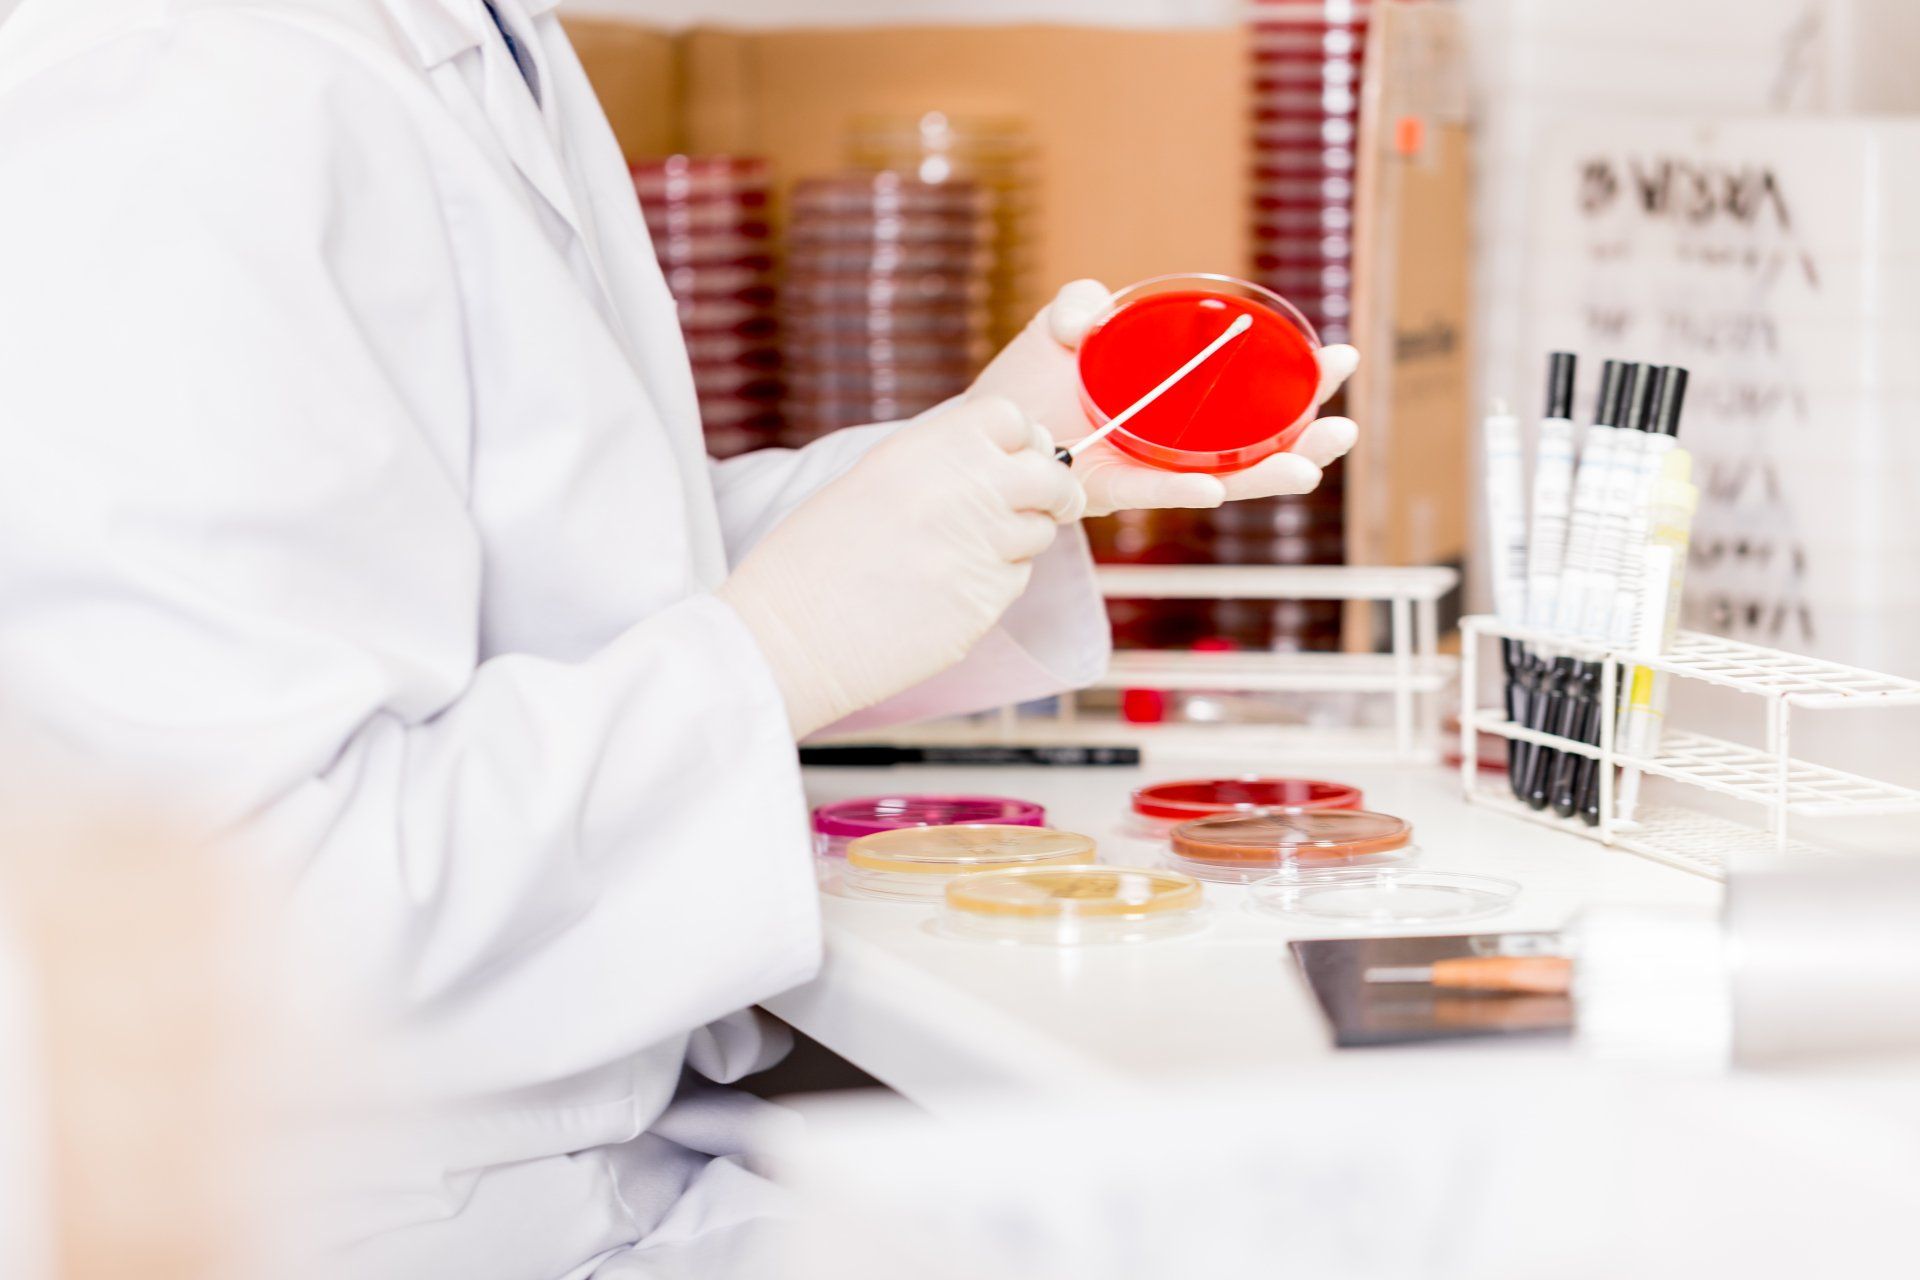

Unsere medizinisches Labor besteht seit nun mehr über 26 Jahren.
In verkehrsgünstiger Lageund Befundbeurteilung.
In verkehrsgünstiger Lage
in Erfurt sind wir ein zuverlässiger Partner für labormedizinische und mikrobiologische Diagnostik, gepaart mit
Befundberatung
Unser Labor befindet sich in Erfurt im Büro- und Gewerbepark in der Blumenstrasse 70, im Haus 3 auf der
3. Etage (Eingang --> roter Pfeil). Sie erreichen uns über die B4, Abfahrt "Gewerbegebiet Blumenstraße".